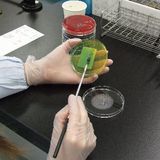

Yoka Hospital 公立八鹿病院

診療:午前8:30~
検査科
診療部門
 |
一人ひとりの技術向上とチームワークの強化により地域医療に貢献します
当院検査科は、医師1名、臨床検査技師19名事務職員0.5名で構成しています。
(令和7年4月1日現在)
(臨床検査技師とは)臨床検査技師は、主に血液の検査(赤血球数や血糖値など)輸血のための検査(血液型など)、 癌細胞を見つけるための病理検査、心電図 脳波 超音波(エコー)など生体に対する 生理機能検査 これら「臨床検査」を行う国家資格です。
臨床検査は、検尿一般検査・血液検査・生化学・免疫・血清検査・微生物検査・病理検査のように尿・血液・喀痰などを分析する検体検査と心電図・呼吸機能・脳波・超音波など人体そのものを対象とする生理機能検査があります。 高度専門医療と病院内外の連携を図るため、人間ドック・超音波(エコー)検診・中央処置室・画像診断科などの部署でも業務をおこなっています。日当直制により24時間365日いつでも正確な検査結果が報告できる体制で診療支援しています。
 |
- 外来検査の迅速な報告体制
昭和61年(1986年)より患者さま中心の医療を提供するため、主な検査は35分以内に各診療科へ報告しています。これにより、受診当日の結果説明が可能であり、早期発見早期治療につながります。腫瘍マーカーや甲状腺マーカーなど特殊な検査も50分で報告しています。
- パニック値への対応
臨床検査の中で「直ちに治療をしなければ生命が危ぶまれる危険な状態の検査結果」これをパニック値といいます。当科では、毎月約9万件の検査を実施しており、その中でパニック値は約80件(0.07%)が該当します。検査結果を最初に見るのは臨床検査技師のため、1人1人が自己研鑽に励み、パニック値を見逃すことなく迅速に医師に報告することで、早期に治療が開始できるよう努めています。
- チーム医療への参画
栄養サポート、糖尿病療養指導、感染対策、抗菌薬適正使用、医療安全などのチーム医療に参加し様々な職種のスタッフと力を合わせて取り組んでいます。
- 認定専門技師の在籍
当院の臨床検査技師は、日々の検査経験や学会・研修会等で研鑽を積み、次のような認定資格を取得したものが在籍しております。
・細胞検査士 2名
・超音波検査士 2名
・糖尿病療養指導士 2名
・認定血液検査技師 1名
・認定輸血検査技師 1名
・心電図検定一級 1名
・緊急臨床検査士 1名
・二級臨床検査士(臨床化学、血液、免疫) 各1名
 |
- 心電図・負荷心電図
心臓の電気的変化を調べる検査で、健康診断や検診でも行われます。狭心症や不整脈など心臓の働きを調べます。 - 心エコー
超音波による心臓の大きさ、動き、血液の流れなどを調べて狭心症や弁膜症、心筋症などの評価を行います。手術前に心臓の働きを調べることもあります。 - 血管エコー
頸動脈:
全身の動脈硬化の指標とされており、首の血管(頸動脈)壁の厚みや血液の流れを調べます。
下肢静脈:
足の深いところにある静脈を観察し、血のかたまりが出来てないかを調べます。手術前に行われることもあります。
下肢動脈:
少し歩くと足が痛くなったり、しびれたりすることで歩けなくなり、少し休むとまた歩けるようになる症状(間欠性跛行)が代表的で、足の動脈の流れを調べます。 - ABI
両手両足の血圧と心電図、心音図を同時に検査します。血管の硬さ(血管年齢)や足の動脈が狭くなっていないかを調べます。 - ホルター心電図
携帯型心電計を24時間装着し、日常生活での心電図を記録して、不整脈の精査や薬剤効果判定を目的におこないます。機器更新により、シャワーでの入浴が可能になりました。
 |
- 呼吸機能
肺活量などを測定して、喘息や肺気腫など肺の病気の診断や経過観察、手術前に肺の状態を調べるために行われます。 - 脳波
脳の働きを調べます。ひきつけや、頭部打撲、意識障害などの方が主な対象となります。 - 耳鼻科検査
聴力や平衡機能(めまい)などの検査を行っています。 - 終夜睡眠ポリグラフィー
一泊入院していただき、夜間睡眠中の無呼吸や酸素不足がおこってないかを調べます。いびきがひどい、昼間の眠気が強い、などの症状のある方が対象になります。 - 誘発筋電図
皮膚の上から神経に電気刺激を与えて、神経の働きを調べます。
 |
生化学検査は血糖値、コレステロール値、電解質など血液中に含まれる成分量を調べます。
免疫血清検査は癌による腫瘍マーカーや感染症による抗原抗体などを調べます。
 |
顕微鏡下の血液像 |
赤血球、白血球、血小板の数や形態を調べたり、血液の凝固能を調べ、貧血、炎症、出血傾向などの評価をします。
 |
顕微鏡下の尿中赤血球 |
尿検査は尿糖、尿蛋白、尿潜血、尿中有形物などを顕微鏡や試薬を使って調べます。
便検査では便潜血、寄生虫などを調べます。
|
痰、尿、便、膿などから病原微生物を検出し、どういった抗菌薬に効果があるか検査します。院内感染の病原菌をいち早く検出したり、検出した細菌の統計処理を行い、院内感染防止対策に貢献しています。また、新型コロナのPCR検査もおこなっています。
 |
病理検査には病理組織検査と細胞診検査があります。
【病理組織検査】
病気の診断や原因を調べるために、手術や検査で採取された組織などから染色標本を作製し、顕微鏡を使って形態学的診断を行います。病気の種類を調べたり、たとえば癌であればその種類、広がりや転移なども調べます。
【細胞診検査】
細胞診検査は病変部から採取した細胞や体液・分泌物から染色標本を作製し、顕微鏡を使って細胞形態を観察します。悪性細胞の有無、感染症の情報などを速く得ることができ、人間ドックや集団検診の中でも利用されています。
安全に輸血が行なえるよう、血液製剤の管理から輸血検査を一貫して行います。また、手術時に自分の血液を輸血する自己血輸血採血を行い、輸血感染症を予防しています。
心電図、肺活量、聴力、視力、超音波などの検査や結果の管理・統計を行っています。
各市町・事業所へ出向いて、腹部・乳腺の超音波検診を行っています。 年間5,000人程の方を検査します。
|
採血、採血管準備、ラベル作成などを行っています。 |












